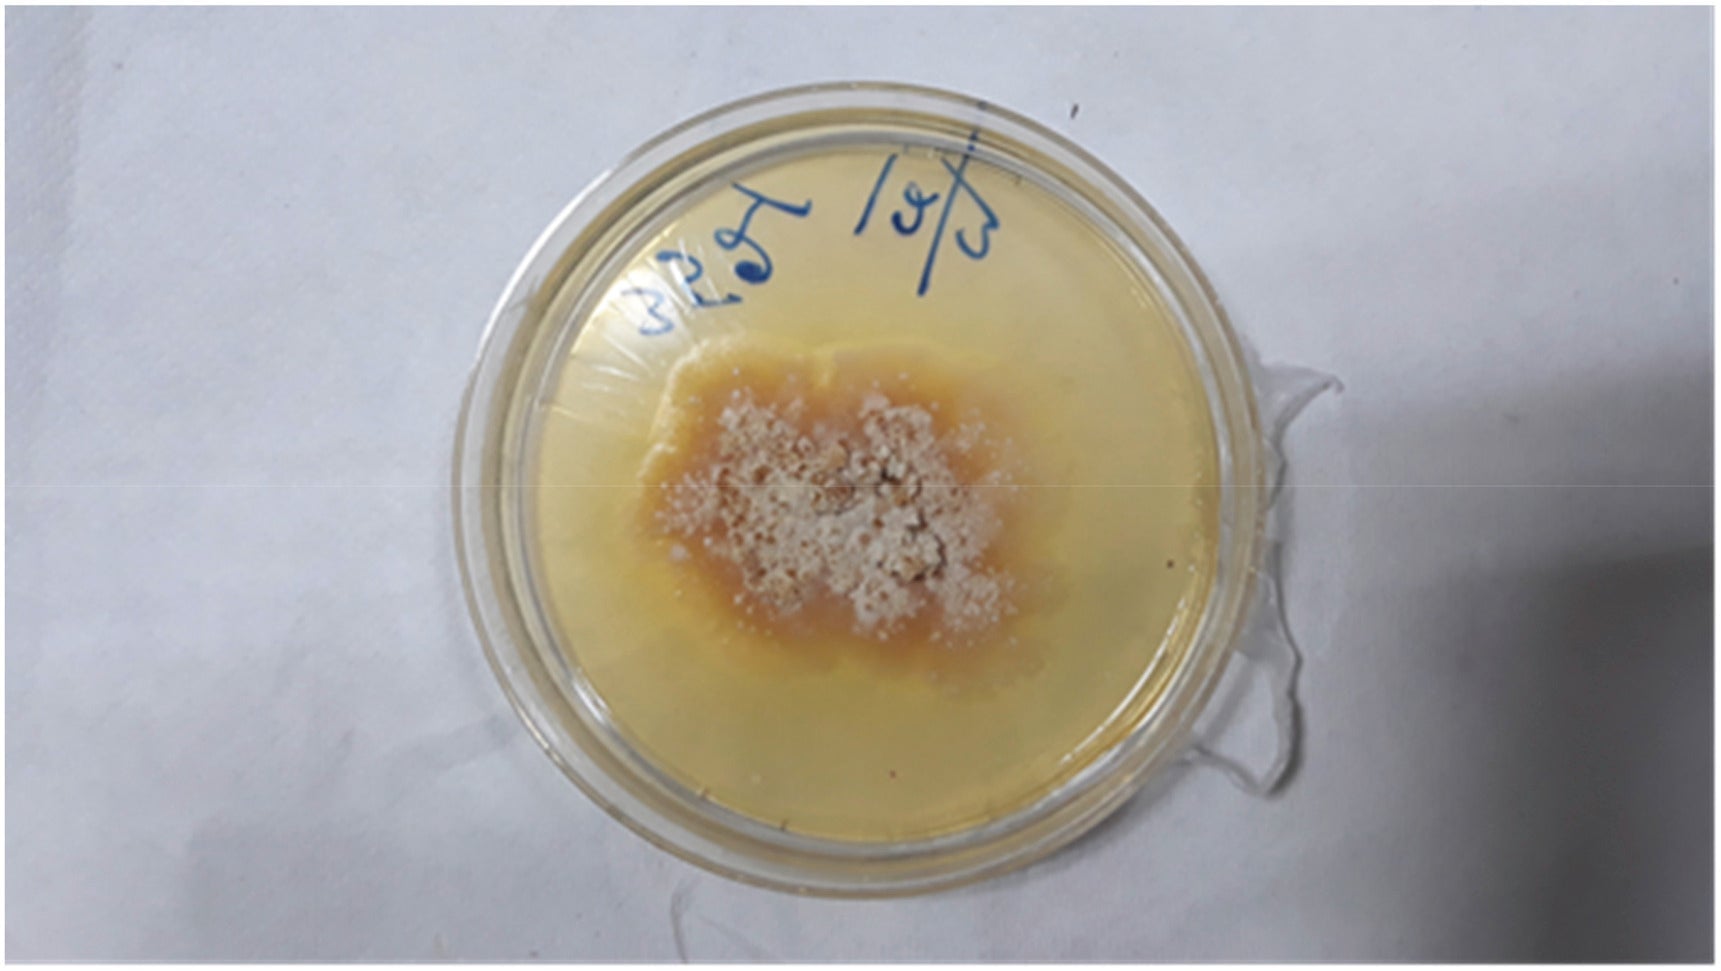
The man’s fungal infection grown in a petri dish.

A man in India recently had the misfortune of becoming the world’s first recorded person to get sick from a fungi that normally attacks rose plants. The case seems to be a rare example of a plant pathogen crossing over into humans. Thankfully, the infection was treatable, but the incident could illustrate the growing danger that fungi will pose to people in the years to come, the doctors say.
The strange medical tale was detailed this month in Medical Mycology Case Reports. According to the report, the 61-year-old man visited an outpatient clinic in India with symptoms of cough, fatigue, sore throat, and trouble swallowing that had gone on for three months. Initial tests soon revealed that he had an abscess (a swollen pocket of pus, often indicating infection) along the right side of his windpipe.
Testing of the pus didn’t yield any common bacterial suspects, but the doctors did find some kind of fungal presence, which was then confirmed by growing it in a petri dish. After sending their samples to another lab affiliated with the World Health Organization, they discovered the likely culprit: a fungus called Chondrostereum purpureum.
C. purpureum causes a disease called silver leaf in plants. It usually infects plants and trees belonging to the rose family, including those responsible for making cherries and plums. The fungus can easily grow on dead or dying wood, but when it latches onto healthy living plants, it often eventually kills them, progressively turning their leaves silver in the process.
Bacteria and other microbes can occasionally jump from one species to another and cause illness. But the less evolutionarily related that two living things are from one another, the harder it is for their parasites to cross over. Pathogens tend to evolve over a long period of time to adapt to their host, and the specific tricks they use to infect and survive inside a plant, for example, aren’t likely to work in a human or other animal. This is perhaps even more true with fungi, since our body temperature is simply too warm for most species to thrive in.
As far as the report authors know, this is the first report of human infection from C. purpureum. Some fungi can regularly infect and make people sick, but these infections tend to happen in people who are immunocompromised. This particular case gets even stranger, since the man had a healthy immune system.
The researchers speculate that it was the man’s job that made him vulnerable to the infection. He was a plant mycologist—a fungi scientist, in other words. And though he reported never studying C. purpureum itself, he did work with decaying plant material and other fungi in his research. They hypothesize that he was exposed to the fungus enough times that it was somehow able to overcome the species barrier.
“Recurrent exposure to the decaying material may be the cause of this rare infection,” the doctors wrote.
Luckily, the man fared much better than the typical rose infected with silver leaf. He had his pus drained and was placed on two months of antifungal medication. His symptoms cleared and, as of two years later, he’s shown no signs of a recurrent infection.
While this case is very likely a fluke, the report authors note that the past few decades have seen a reported rise in human fungal pathogens. Some scientists even theorize that our warming climate is enabling some fungi to become better suited to humans, though this is still an actively debated hypothesis. And if plant fungi can rarely cross over and infect people or other animals, that’s a discovery with “important implications for the emergence of infectious diseases,” the authors say. Much more research will have to be done to study the potential mechanisms involved in these “cross-kingdom” infections, they add.